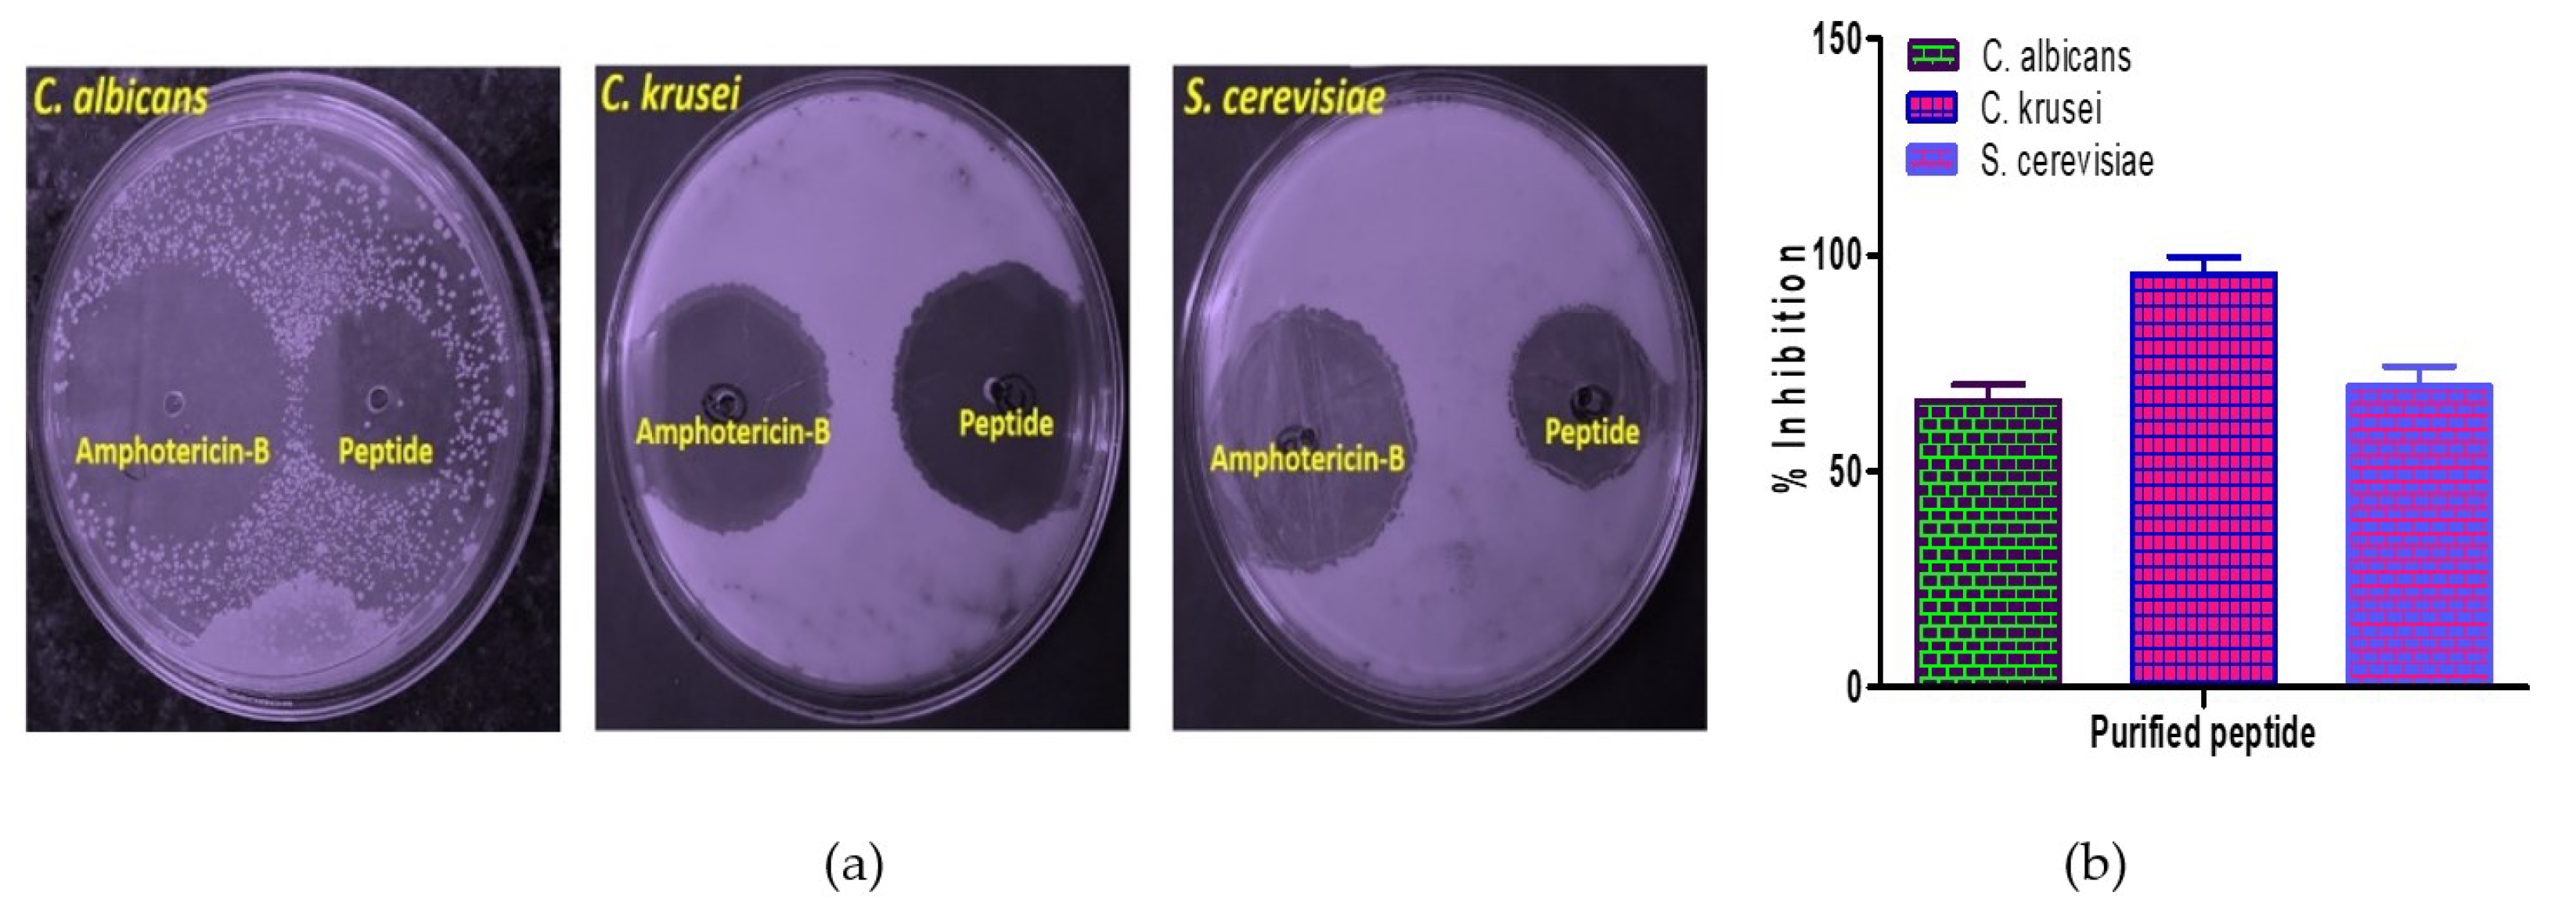

RETRACTED: Chickpea Peptide: A Nutraceutical Molecule Corroborating Neurodegenerative and ACE-I Inhibition
Abstract
1. Introduction
2. Materials and Methods
2.1. Preparation of Protein Concentrates and Enzymatic Hydrolysis
2.2. Ultrafiltration and Purification by FPLC
2.3. Amino Acid Composition Analysis
2.4. Assay and Kinetics of ACE-I Inhibition
2.5. Biophysical Activity
2.5.1. Far-UV Circular Dichroism Measurements
2.5.2. ThT Fluorescence Measurements
2.5.3. Differential Scanning Calorimetry (DSC)
2.5.4. Infra-Red Spectroscopic Analysis
2.5.5. Identification of Peptide by LC–MS
2.6. Biochemical Characterization
2.6.1. Assay of Antibacterial Activity
2.6.2. Assay of Antifungal Activity
2.6.3. Assessment of DNA Damage
2.6.4. Protein Oxidation Assay
2.7. Antidiabetic Assay
2.7.1. α-Amylase Inhibition Assay
2.7.2. α-Glucosidase Inhibition Assay
2.8. In Vivo Studies
2.8.1. Animal Management
2.8.2. Antihypertensive Effects
3. Result and Discussion
3.1. Chickpea Protein Hydrolysate and Its Ultra-Filtered Fractions
3.2. Separation by FPLC
3.3. Amino Acid Composition of Fractions
3.4. The Inhibition Pattern of the Purified Peptides against ACE
3.5. ThT Binding Assay
3.6. Secondary Structural Modulation
3.7. DSC
3.8. FTIR
3.9. Identification of Bioactive Peptides by LC-MS
3.10. Antimicrobial Activity
Antibacterial and Antifungal Activity
3.11. Inhibition of Oxidative DNA Damage
3.12. Protein Oxidation Assay
3.13. α-Amylase Inhibitory Activity of Chickpea Peptides
3.14. α-Glucosidase Inhibitory Activity of Chickpea Peptides
3.15. Antihypertensive Effects of Chickpea Bioactive Peptide in Hypertensive Rats
4. Conclusions
Author Contributions
Funding
Institutional Review Board Statement
Informed Consent Statement
Data Availability Statement
Conflicts of Interest
References
- Chiti, F.; Dobson, C.M. Protein misfolding, functional amyloid and human disease. Annu. Rev. Biochem. 2006, 75, 333–366. [Google Scholar] [CrossRef] [PubMed]
- Chaturvedi, S.K.; Siddiqi, M.K.; Alam, P.; Khan, R.H. Protein misfolding and aggregation: Mechanism, factors and detection. Process Biochem. 2016, 51, 1183–1192. [Google Scholar] [CrossRef]
- Walsh, D.M.; Teplow, D.B. Alzheimer’s disease and the amyloid β-protein. Prog. Mol. Biol. Trans. Sci. 2012, 107, 101–124. [Google Scholar]
- Soto, C. Unfolding the role of protein misfolding in neurodegenerative diseases. Nat. Rev. Neurosci. 2003, 4, 49–60. [Google Scholar] [CrossRef] [PubMed]
- Ivanova, M.I.; Sievers, S.A.; Sawaya, M.R.; Wall, J.S.; Eisenberg, D. Molecular basis for insulin fibril assembly. Proc. Natl. Acad. Sci. USA 2009, 106, 18990–18995. [Google Scholar] [CrossRef]
- Jayamani, J.; Shanmugam, G. Gallic acid, one of the components in many plant tissues, is a potential inhibitor for insulin amyloid fibril formation. Eur. J. Med. Chem. 2014, 85, 352–358. [Google Scholar] [CrossRef]
- Swaminathan, R.; Ravi, V.K.; Kumar, S.; Kumar, M.V.S.; Chandra, N. Lysozyme: A model protein for amyloid research. Adv. Protein Chem. Struct. Biol. 2011, 84, 63–111. [Google Scholar]
- Hirota-Nakaoka, N.; Hasegawa, K.; Naiki, H.; Goto, Y. Dissolution of β2-microglobulin amyloid fibrils by dimethylsulfoxide. J. Biochem. 2003, 134, 159–164. [Google Scholar] [CrossRef]
- Gupta, N.; Srivastava, N.; Bhagyawant, S.S. Vicilin—A major storage protein of mungbean exhibits antioxidative potential, antiproliferative effects and ACE inhibitory activity. PLoS ONE 2018, 13, e0191265. [Google Scholar] [CrossRef]
- Gupta, N.; Bhagyawant, S.S. Enzymatic treatment improves ACE-I inhibiton and antiproliferative potential of chickpea. Vegetos 2019, 32, 363–369. [Google Scholar] [CrossRef]
- Gupta, N.; Srivastava, N.; Singh, P.K.; Bhagyawant, S.S. Phytochemical evaluation of moth bean (Vigna aconitifolia L.) seeds and their divergence. Biochem. Res. Int. 2016, 2016, 3136043. [Google Scholar] [CrossRef] [PubMed]
- Gupta, N.; Shrivastava, N.; Bhagyawant, S.S. Multivariate analysis based on nutritional value, antinutritional profile and antioxidant capacity of forty chickpea genotypes grown in India. J. Nutr. Food Sci. 2017, 7, 3. [Google Scholar] [CrossRef]
- Gupta, N.; Tiwari, S.; Tripathi, M.K.; Bhagyawant, S.S. Antinutritional and protein based profiling of diverse desi and wild chickpea accessions. Curr. J. Appl. Sci. Technol. 2021, 40, 7–18. [Google Scholar] [CrossRef]
- Bhagyawant, S.S.; Gautum, A.K.; Narvekar, D.T.; Gupta, N.; Bhadkaria, A.; Srivastava, N.; Upadhyaya, H.D. Biochemical diversity evaluation in chickpea accessions employing mini-core collection. Physiol. Mol. Biol. Plants 2018, 24, 1165–1183. [Google Scholar] [CrossRef] [PubMed]
- Bhagyawant, S.S.; Gupta, N.; Srivastava, N. Biochemical analysis of chickpea accessions vis-a-vis; zinc, iron, total protein, proline and antioxidant activity. Am. J. Food Sci. Technol. 2015, 3, 158–162. [Google Scholar]
- Erdmann, K.; Cheung, B.W.Y.; Schroder, H. The possible roles of food-derived bioactive peptides in reducing the risk of cardiovascular disease. J. Nutr. Biochem. 2008, 19, 643–654. [Google Scholar] [CrossRef]
- Ghribi, A.M.; Sila, A.; Przybylski, R.; Arroume, N.N.; Makhlouf, I.; Blecker, C.; Attia, H.; Dhulster, P.; Bougatef, A.; Besbes, S. Purification and identification of novel antioxidant peptides from enzymatic hydrolysate of chickpea (Cicer arietinum L.) protein concentrate. J. Funct. Food 2015, 12, 516–525. [Google Scholar] [CrossRef]
- Zhang, T.; Li, Y.H.; Miao, M.; Jiang, B. Purification and characterization of a new antioxidant peptide from chickpea (Cicer arietinum L.) protein hydrolysates. Food Chem. 2011, 128, 28–33. [Google Scholar] [CrossRef]
- Udenigwe, C.C.; Aluko, R.E. Food protein-derived bioactive peptides: Production, processing, and potential health benefits. J. Food Sci. 2012, 77, 11–24. [Google Scholar] [CrossRef]
- Gautam, A.K.; Gupta, N.; Narvekar, D.T.; Bhadkariya, R.; Bhagyawant, S.S. Characterization of chickpea (Cicer arietinum L.) lectin for biological activity. Physiol. Mol. Biol. Plants 2018, 24, 389–397. [Google Scholar] [CrossRef]
- Gupta, N.; Bhagyawant, S.S. Angiotensin-I converting enzyme (ACE-I) inhibitory and antiproliferative potential of chickpea seed protein hydrolysate. Ann. Plant Sci. 2018, 7, 2149–2153. [Google Scholar] [CrossRef][Green Version]
- Li, G.H.; Le, G.W.; Shi, Y.H.; Shrestha, S. Angiotensin I-converting enzyme inhibitory peptides derived from food proteins and their physiological and pharmacological effects. Nutr. Res. 2004, 27, 469–486. [Google Scholar] [CrossRef]
- Vermeirssen, V.; Augustijns, P.; Morel, N.; Camp, J.V.; Opsomer, A.; Verstraete, W. In vitro intestinal transport and antihypertensive activity of ACE inhibitory pea and whey digests. Int. J. Food Sci. Nutr. 2005, 56, 415–430. [Google Scholar] [CrossRef] [PubMed]
- Yust, M.; Pedroche, J.; Girón-Calle, J.; Alaiz, M.; Millán, F.; Vioque, J. Production of ace inhibitory peptides by digestion of chickpea legumin with alcalase. Food Chem. 2003, 81, 363–369. [Google Scholar] [CrossRef]
- Kou, X.; Gao, J.; Xue, Z.; Zhang, Z.; Wang, H.; Wang, X. Purification and identification of antioxidant peptides from chickpea (Cicer arietinum L.) albumin hydrolysates. LWT Food Sci. Technol. 2013, 50, 591–598. [Google Scholar] [CrossRef]
- Bradford, M.M. A rapid and sensitive method for the quantitation of microgram quantities of protein utilizing the principle of protein–dye binding. Anal. Biochem. 1976, 72, 248–254. [Google Scholar] [CrossRef]
- Chale, F.G.H.; Ruiz, J.C.R.; Fernandez, J.J.A.; Ancona, D.A.B.; Campos, M.R.S. ACE inhibitory hypotensive and antioxidant peptide fractions from (Mucuna pruriens) proteins. Process Biochem. 2014, 49, 1691–1698. [Google Scholar] [CrossRef]
- Cushman, D.W.; Cheung, H.S. Spectrophotometric assay and properties of the angiotensin-converting enzyme of rabbit lung. Biochem. Pharmacol. 1971, 20, 1637–1648. [Google Scholar] [CrossRef]
- Raheleh, J.; Mahmood, G.; Kourosh, V.; Maryam, S.; Mohammadreza, K.; Nader, S.; Ali, A.M.M. Kinetics of protein hydrolysis and inhibition of angiotensin converting enzyme by peptides hydrolysate extracted from walnut. Int. J. Pept. Res. Ther. 2017, 24, 77–85. [Google Scholar]
- Chaturvedi, S.K.; Alam, P.; Khan, J.M.; Siddiqui, M.K.; Kalaiarasan, P.; Subbarao, N.; Ahmad, Z.; Khan, R.H. Biophysical insight into the anti-amyloidogenic behavior of taurine. Int. J. Biol. Macromol. 2015, 80, 375–384. [Google Scholar] [CrossRef]
- Gautam, A.K.; Srivastava, N.; Nagar, D.P.; Bhagyawant, S.S. Biochemical and functional properties of a lectin purified from the seeds of Cicer arietinum L. 3 Biotech 2018, 8, 272. [Google Scholar] [CrossRef] [PubMed]
- Bhagyawant, S.S.; Narvekar, D.T.; Gupta, N.; Bhadkaria, A.; Gautam, A.K.; Srivastava, N. Chickpea (Cicer arietinum L.) lectin exhibit inhibition of ACE-I, α-amylase and α-glucosidase activity. Protein Pept. Lett. 2019, 26, 494–501. [Google Scholar] [CrossRef] [PubMed]
- Laemmli, U.K. Cleavage of structural proteins during the assembly of the head of bacteriophage T4. Nature 1970, 227, 680–685. [Google Scholar] [CrossRef]
- Yu, Z.; Yin, Y.; Zhao, W.; Liu, J.; Chen, F. Anti-diabetic activity peptides from albumin against α-glucosidase and α-amylase. Food Chem. 2012, 135, 2078–2085. [Google Scholar] [CrossRef] [PubMed]
- Linardi, A.; Panunto, P.C.; Ferro, E.S.; Hyslop, S. Peptidase activities in rats treated chronically with N (omega)-nitro-L-arginine methyl ester (L-NAME). Biochem. Pharmacol. 2004, 68, 205–214. [Google Scholar] [CrossRef] [PubMed]
- Fuglsang, A.; Rattray, F.P.; Nilsson, D.; Nyborg, N.C. Lactic acid bacteria: Inhibition of angiotensin converting enzyme in vitro and in vivo. Antonie Leeuwenhoek 2003, 83, 27–34. [Google Scholar] [CrossRef]
- Sharma, S.; Singh, R.; Rana, S. Bioactive peptides: A review. Int. J. Bioautom. 2011, 15, 223–250. [Google Scholar]
- Cheung, H.S.; Wang, F.L.; Ondetti, M.A.; Sabo, E.F.; Cushman, D.W. Binding of peptide substrates and inhibitors of angiotensin-converting enzyme. J. Biol. Chem. 1980, 255, 401–407. [Google Scholar] [CrossRef]
- Tang, C.H.; Sun, X. Physicochemical and structural properties of 8S and/or 11S globulins from mungbean [Vigna radiate (L.)]. J. Agric. Food Chem. 2010, 58, 6395–6402. [Google Scholar] [CrossRef]
- Tang, C.H.; Sun, X. A comparative study of physicochemical and conformational properties in three vicilins from Phaseolus legumes: Implications for the structure-function relationship. Food Hydrocoll. 2011, 25, 315–324. [Google Scholar] [CrossRef]
- Shevkani, K.; Singh, N.; Kaur, A.; Rana, J.C. Structural and functional characterization of kidney bean and field pea protein isolates: A comparative study. Food Hydrocoll. 2015, 43, 679–689. [Google Scholar] [CrossRef]
- Lai, F.; Wen, Q.; Li, L.; Wu, H.; Li, X. Antioxidant activities of water-soluble polysaccharide extracted from mung bean (Vigna radiata L.) hull with ultrasonic assisted treatment. Carbohydr. Polym. 2010, 81, 323–329. [Google Scholar] [CrossRef]
- Kacurakova, M.; Capek, P.; Sasinkova, V.; Wellner, N.; Ebringerova, A. FT-IR study of plant cell wall model compounds: Pectic polysaccharides and hemicelluloses. Carbohydr. Polym. 2000, 243, 195–203. [Google Scholar] [CrossRef]
- Megías, C.; Yust, M.M.; Pedroche, J.; Lquari, H.; Giron-Calle, J.; Aliaiz, M.; Millan, F.; Vioque, J. Purification of an ACE inhibitory peptide after hydrolysis of sunflower (Helianthus annuus L.) protein isolates. J. Agric. Food Chem. 2004, 52, 1928–1932. [Google Scholar] [CrossRef] [PubMed]
- Wu, J.; Ding, X. Hypotensive and physiological effect of angiotensin converting enzyme inhibitory peptides derived from soy protein on spontaneously hypertensive rats. J. Agric. Food Chem. 2001, 49, 501–506. [Google Scholar] [CrossRef] [PubMed]
- Lee, S.Y.; Hur, S.J. Antihypertensive peptides from animal products, marine organisms and plants. Food Chem. 2017, 228, 506–517. [Google Scholar] [CrossRef]
- Daskaya-Dikmen, C.; Yucetepe, A.; Karbancioglu-Guler, F.; Ozcelik, B.; Daskaya, H. Angiotensin-I-Converting Enzyme (ACE)-Inhibitory peptides from plants. Nutrients 2017, 9, 316. [Google Scholar] [CrossRef]
- Kobayashi, Y.; Yamauchi, T.; Katsuda, T.; Yamaji, H.; Katoh, S. Angiotensin-I converting enzyme (ACE) inhibitory mechanism of tripeptides containing aromatic residues. J. Biosci. Bioeng. 2008, 106, 310–312. [Google Scholar] [CrossRef]
- Martinez-Maqueda, D.; Miralles, B.; Recio, I.; Hernandez-Ledesma, B. Antihypertensive peptides from food proteins: A review. Food Funct. 2012, 3, 350–361. [Google Scholar] [CrossRef]
- Himaya, S.W.A.; Ngo, D.H.; Ryu, B.; Kim, S.K. An active peptide purified from gastrointestinal enzyme hydrolysate of Pacific cod skin gelatin attenuates angiotensin-1converting enzyme (ACE) activity and cellular oxidative stress. Food Chem. 2012, 132, 1872–1882. [Google Scholar] [CrossRef]
- Wang, X.; Chen, H.; Fu, X.; Li, S.; Wei, J. A novel antioxidant and ACE inhibitory peptide from rice bran protein: Biochemical characterization and molecular docking study. LWT Food Sci. Technol. 2017, 75, 93–99. [Google Scholar] [CrossRef]
- Taroco, R.; Seija, V.; Vignoli, R. Chapter 36. In Métodos de Estudio de la Sensibilidad Antibiótica; Chapingo: Texcoco, Mexico, 2006; pp. 663–671. [Google Scholar]
- Gupta, N.; Gautam, A.K.; Bhagyawant, S.S. Biochemical characterization of lectin from wild chickpea (Cicer reticulatum L.) with potential inhibitory action against human cancer cells. J. Food Biochem. 2018, 43, e12712. [Google Scholar] [CrossRef] [PubMed]
- Gupta, N.; Bisen, P.S.; Bhagyawant, S.S. Chickpea lectin inhibits human breast cancer cell proliferation and induces apoptosis through cell cycle arrest. Protein Pept. Lett. 2018, 25, 492–499. [Google Scholar] [CrossRef]
- Jenssen, H.; Hamill, P.; Hancock, E.W. Peptide antimicrobial agents. Clin. Microbiol. Rev. 2006, 19, 491–511. [Google Scholar] [CrossRef] [PubMed]
- Izadpanah, A.; Gallo, R.L. Antimicrobial peptides. J. Am. Acad. Dermatol. 2005, 52, 381–390. [Google Scholar] [CrossRef] [PubMed]
- Odintsova, T.; Egorov, R. Chapter plant antimicrobial peptides. In Plant Signaling Peptides; Irving, H.R., Gehring, C., Eds.; Springer: Melbourne, Australia, 2012; pp. 107–133. [Google Scholar]
- Wong, J.H.; Ng, T.B. Lunatusin, a trypsin-stable antimicrobial peptide from lima beans (Phaseolus lunatus L.). Peptides 2005, 26, 2086–2092. [Google Scholar] [CrossRef] [PubMed]
- Wong, J.H.; Zhang, X.Q.; Wang, H.X.; Ng, T.B. A mitogenic defensing from white cloud beans (Phaseolus vulgaris). Peptides 2006, 27, 2075–2081. [Google Scholar] [CrossRef]
- Mine, Y.; Ma, F.; Lauriau, S. Antimicrobial peptides released by enzymatic hydrolysis of hen egg white lysozyme. J. Agric. Food Chem. 2004, 52, 1088–1094. [Google Scholar] [CrossRef]
- Song, R.; Wei, R.B.; Luo, H.Y.; Wang, D.F. Isolation and characterization of an antibacterial peptide fraction from the pepsin hydrolysate of half-fn Anchovy (Setipinna taty). Molecules 2012, 17, 2980–2991. [Google Scholar] [CrossRef]
- Shih, M.K.; Hu, M.L. UVA-potentiated damage to calf thymus DNA by Fenton reaction system and protection by para amino benzoic acid. Photochem. Photobiol. 1996, 63, 286–291. [Google Scholar] [CrossRef]
- Martinez, G.R.; Loureiro, A.P.; Marques, S.A.; Miyamoto, S.; Yamaguchi, L.F.; Onuki, J. Oxidative and alkylating damage in DNA. Mutat. Res. 2003, 544, 115–127. [Google Scholar] [CrossRef] [PubMed]
- Bhagyawant, S.S.; Narvekar, D.T.; Gupta, N.; Bhadkaria, A.; Koul, K.K.; Srivastava, N. Variations in the antioxidant and free radical scavenging under induced heavy metal stress expressed as proline content in chickpea. Physiol. Mol. Biol. Plants 2019, 25, 683–696. [Google Scholar] [CrossRef] [PubMed]
- Gautam, A.K.; Gupta, N.; Srivastava, N.; Bhagyawant, S.S. Proteomic analysis of chickpea roots reveal differential expression of abscisic acid responsive proteins. J. Food Biochem. 2019, 43, e12838. [Google Scholar] [CrossRef] [PubMed]
- Gropper, S.S.; Smith, J.L. Advanced Nutrition and Human Metabolism; Yalanda Cossio Inc.: Belmont, Australia, 2013. [Google Scholar]
- Wilson, A.L.; Mehra, I.V. Managing the Patient with Type II Diabetes; Aspen Publishers: Gaithersburg, ML, USA, 1997. [Google Scholar]
- Connolly, A.; Piggott, C.O.; FitzGerald, R.J. In vitro-glucosidase, angiotensin converting enzyme and dipeptidyl peptidase-IV inhibitory properties of brewers’ spent grain protein hydrolysates. Food Res. Int. 2014, 56, 100–107. [Google Scholar] [CrossRef]
- Gupta, N.; Bhagyawant, S.S. Impact of hydrolysis on functional properties, antioxidant, ACE-I inhibitory and anti-proliferative activity of Cicer arietinum and Cicer reticulatum hydrolysates. Nutrire 2019, 44, 5. [Google Scholar] [CrossRef]
- Gupta, N.; Bhagyawant, S.S. Bioactive peptide of Cicer arietinum L. induces apoptosis in human endometrial cancer via DNA fragmentation and cell cycle arrest. 3 Biotech 2021, 11, 63. [Google Scholar] [CrossRef] [PubMed]
- Ercan, P.; Nehir EI, S. Inhibitory effects of chickpea and Tribulus terrestris on lipase, α-amylase and α-glucosidase. Food Chem. 2016, 205, 163–169. [Google Scholar] [CrossRef]
- Uraipong, C.; Zhao, J. Rice bran protein hydrolysates exhibit strong in vitro α-amylase, β-glucosidase and ACE-inhibition activities. J. Sci. Food Agric. 2016, 96, 1101–1110. [Google Scholar] [CrossRef]
- Podsędek, A.; Majewska, I.; Redzynia, M.; Sosnowska, D.; Koziołkiewicz, M. In vitro inhibitory effect on digestive enzymes and antioxidant potential of commonly consumed fruits. J. Agric. Food Chem. 2014, 62, 4610–4617. [Google Scholar] [CrossRef]
- Kajaria, D.; Ranjana; Tripathi, J.; Tripathi, Y.B.; Tiwari, S. In-vitro α amylase and glycosidase inhibitory effect of ethanolic extract of antiasthmatic drug—Shirishadi. J. Adv. Pharm. Technol. Res. 2013, 4, 206–209. [Google Scholar] [CrossRef]
- Nagmoti, D.M.; Juvekar, A.R. In vitro inhibitory effects of Pithecellobium dulce (Roxb.) Benth seeds on intestinal α-glucosidase and pancreatic α-amylase. J. Biochem. Technol. 2013, 4, 616–621. [Google Scholar]
- Li, G.H.; Shi, Y.H.; Liu, H.; Le, G.W. Antihypertensive effect of Alcalase® generated mung bean protein hydrolysates in spontaneously hypertensive rats. Eur. Food Res. Technol. 2006, 222, 733–736. [Google Scholar] [CrossRef]

| Ultra Filtered Fraction (kDa) | ACE-I Inhibitory Activity IC50 Value (µg/mL) |
|---|---|
| 10 | 110.3 ± 0.070 |
| 5–10 | 125.1 ± 0.22 |
| 3–5 | 109.7 ± 0.98 |
| 3 | 104.9 ± 1.27 |
| Crude protein | 140.9 ± 0.084 |
| Captopril | 86.79 ± 2.09 |
| Procedure | Yield (mg/g Protein) |
|---|---|
| Crude protein | 21.5 |
| After hydrolysis | 17.4 |
| After ultrafiltration | 10.1 |
| After purification by FPLC system | 6.1 |
| Amino Acid | Chickpea Protein | Alcalase Hydrolysate |
|---|---|---|
| Aspartic acid | 14.4 ± 1.24 | 11.2 ± 0.29 |
| Glutamic acid | 18.5 ± 0.21 | 15.6 ± 0.31 |
| Serine | 7.1 ± 1.20 | 5.8 ± 0.20 |
| Histidine | 3.0 ± 0.42 | 2.4 ± 0.22 |
| Glycine | 3.8 ± 0.11 | 3.1 ± 0.11 |
| Threonine | 4.0 ± 0.36 | 3.2 ± 0.16 |
| Arginine | 13.6 ± 0.28 | 10.6 ± 0.14 |
| Alanine | 3.74 ± 2.60 | 4.1 ± 0.60 |
| Tyrosine | 3.1 ± 0.31 | 2.9 ± 0.19 |
| Valine | 3.9 ± 0.29 | 3.0 ± 0.29 |
| Methionine | 1.41 ± 0.27 | 1.01 ± 0.12 |
| Cystine | 1.3 ± 0.38 | 1.1 ± 0.20 |
| Isoleucine | 4.4 ± 1.08 | 4.2 ± 1.18 |
| Leucine | 9.7 ± 1.43 | 9.2 ± 0.61 |
| Phenylalanine | 7.3 ± 1.56 | 5.7 ± 0.16 |
| Lysine | 7.1 ± 0.46 | 6.9 ± 0.12 |
| Kinetic Parameters | 0 mg/mL (No Inhibitor) | 0.1 mg/mL | 0.25 mg/mL |
|---|---|---|---|
| Vmax (nm) | 0.1149 | 0.1434 | 0.3279 |
| Km (mM) | 0.08212 | 0.07936 | 0.09130 |
| Ki (mg/mL) | 00 | 4.199 | 4.845 |
Publisher’s Note: MDPI stays neutral with regard to jurisdictional claims in published maps and institutional affiliations. |
© 2022 by the authors. Licensee MDPI, Basel, Switzerland. This article is an open access article distributed under the terms and conditions of the Creative Commons Attribution (CC BY) license (https://creativecommons.org/licenses/by/4.0/).
Share and Cite
Gupta, N.; Quazi, S.; Jha, S.K.; Siddiqi, M.K.; Verma, K.; Sharma, S.; Khan, R.H.; Bhagyawant, S.S. RETRACTED: Chickpea Peptide: A Nutraceutical Molecule Corroborating Neurodegenerative and ACE-I Inhibition. Nutrients 2022, 14, 4824. https://doi.org/10.3390/nu14224824
Gupta N, Quazi S, Jha SK, Siddiqi MK, Verma K, Sharma S, Khan RH, Bhagyawant SS. RETRACTED: Chickpea Peptide: A Nutraceutical Molecule Corroborating Neurodegenerative and ACE-I Inhibition. Nutrients. 2022; 14(22):4824. https://doi.org/10.3390/nu14224824
Chicago/Turabian StyleGupta, Neha, Sameer Quazi, Saurabh Kumar Jha, Mohammad Khursheed Siddiqi, Kanika Verma, Swapnil Sharma, Rizwan Hassan Khan, and Sameer Suresh Bhagyawant. 2022. "RETRACTED: Chickpea Peptide: A Nutraceutical Molecule Corroborating Neurodegenerative and ACE-I Inhibition" Nutrients 14, no. 22: 4824. https://doi.org/10.3390/nu14224824
APA StyleGupta, N., Quazi, S., Jha, S. K., Siddiqi, M. K., Verma, K., Sharma, S., Khan, R. H., & Bhagyawant, S. S. (2022). RETRACTED: Chickpea Peptide: A Nutraceutical Molecule Corroborating Neurodegenerative and ACE-I Inhibition. Nutrients, 14(22), 4824. https://doi.org/10.3390/nu14224824

